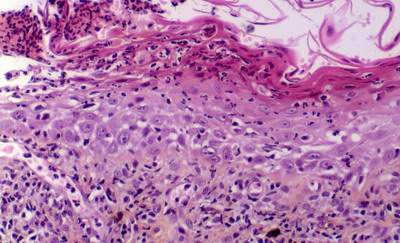
Un cas de pemphigus érythémateux canin

Auteur : Christian Collinot
Clinique vétérinaire du ROC
117, avenue du maréchal LECLERC
86100 CHATELLERAULT
Commémoratifs
Adagio est un Schipperke mâle de cinq ans et demi, inscrit au Livre des Origines Français. Il est l’étalon d’un élevage amateur et fait de nombreuses expositions. Il vit avec d’autres chiennes de sa race et leurs chiots en attente de la vente ou futurs reproducteurs. Il n’a jamais présenté de problème de santé particulier hors quelques laryngo-trachéites traitées par antibiothérapie et corticoïdes. Le dernier épisode remonte à plus de huit mois lors de la consultation.
Anamnèse
Il y a cinq mois, il a été traité avec succès pour une mycose du chanfrein, par de l’énilconazole (Imavéral ND) localement sur la lésion. Quatre mois plus tard, une irritation du chanfrein prise pour une récidive, a été traitée sans diagnostic plus poussé. Nous sommes au milieu de l’été. Nous voyons l’animal un mois plus tard, pour l’examen actuel, les lésions continuent à évoluer, avec atteinte de la truffe. Il est amené pour la présence de ces lésions nasales et péri nasales associées à une dépigmentation esthétiquement très affligeantes, surtout pour un animal de concours.
Examen clinique
Examen général
Il n’y a rien à signaler, l’embonpoint est un peu supérieur à la moyenne.
Examen dermatologique
On note:
- des lésions érythémateuses discrètes de la jonction entre le truffe et le chanfrein, avec présence de quelques squames;
- une plaque érythémateuse et alopécique au cantus externe de l’œil gauche, une seconde plus large en partie médiane de la lèvre inférieure;
- une dépigmentation importante de la truffe associée à un léger érythème, quelques squames croûtes et une ulcération des narines;
- aucune autre lésion sur le reste du corps.
Nous sommes donc en présence de lésions dépigmentées, érythémateuses, légèrement squamo-croûteuses et érosives atteignant principalement la truffe et le chanfrein.
Hypothèses cliniques
Nous construirons nos hypothèses étiologiques en repartant, dans un premier temps, des différentes composantes lésionnelles, puis en discutant ces hypothèses. Cette atteinte préférentielle de la truffe nous fait éliminer les pathologie de la peau stricto sensu et en particulier du follicule et du poil comme la folliculite bactérienne, la démodécie, les dermatomycoses; l’absence d’atteinte oculaire, un syndrome uvéo-cutané; l’absence de douleur et l’évolution lente, un accident cutané médicamenteux. Enfin l’absence de prurit n’est pas en faveur d’un phénomène allergique.
Hypothèses en fonction des lésions
- Dépigmentation
- Vitiligo
- Cicatrice
- Hyperkératose
- Maladie Auto-Immune (Lupus, Pemphigus)
- Leishmaniose
- Dermatose répondant au Zinc
- Érythème
- M.A.I.
- Leishmaniose
- Ulcérations
- M.A.I.
- Leishmaniose
- Épithélioma ou autre néoplasie
Arguments qui ne sont pas en faveur d’une hypothèse
- Vitiligo: lésions inflammatoires et érosives
- D. améliorée par le Zinc: faible hyperkératose et peu de lésions de la face, (âge pour le type I)
- Leishmaniose: pas de passage dans une zone à risque, pas de signes généraux
- Néoplasie: atteinte d’emblée multicentrique.
Examens complémentaires
L’histologiste se retrouve au premier plan puisqu’il intervient dans toutes les hypothèses. Les biopsies cutanées seront donc l’examen de choix.
L’immunologie nous apportera son secours dans le cas des MAI, des biopsies seront conservées dans du milieu de Michel pour une immunofluorescence directe. La sérologie sera utile pour la leishmaniose et l’élimination d’un Lupus systémique.
La cytologie (copeau de peau, ponction ganglionnaire, ponction de moelle osseuse) permet la recherche de Leishmanies.
* Résultats des examens complémentaires:
Histologie
“On remarque en surface un épiderme acanthosique et relativement spongiotique. Par endroits apparaissent des exulcérations d’assez grande taille. Celle-ci sont recouvertes par des croûtes massivement infiltrées par des polynucléaires dégénérés (+ des acanthocytes). L’attention est ensuite attirée par de nombreuses images de dégénerescence hydropique cantonnées sur la couche basale .
Enfin sur une section, l’attention est immédiatement attirée par la présence d’ une pustule située sur la paroi folliculaire. Celle-ci contient des polynucléaires neutrophiles et de nombreux acanthocytes.
Le derme superficiel fait l’objet d’une infiltration lichénoïde lymphoplasmocytaire. On remarque de plus une incontinence pigmentaire intense.
Absence de parasites et d’éléments mycéliens.”
Immunofluorescence directe
Présence d’une fluorescence linéaire à la jonction dermo-épidermique (conjugué utilisé: anti-IgG, anti-C3).
Sérologie de Leishmaniose
Négative.
Diagnostic
L’histologie nous donne la clé du diagnostic étiologique. Ces lésions associant une acantholyse sous cornée et une dermatite lichénoïde d’interface de type lupique, sont caractéristiques d’une dermatose, relativement rare, intermédiaire entre le pemphigus foliacé et le lupus discoïde, décrite uniquement chez le chien et le chat: le PEMPHIGUS ERYTHEMATEUX. L’immunofluorescence directe a permis de retrouver uniquement le dépôt d’immunoglobulines et/ou de complément le long de la membrane basale de l’épiderme mais pas celle au niveau des espaces intercellulaires.
Traitement
Le traitement tient compte du fait que les lésions de la truffe rendent Adagio inapte à son rôle. On utilise donc des corticoïdes (prednisolone) a une dose de départ légèrement supérieure à 2mg/kg/j en une prise le matin et de la vitamine E (EPHYNAL ND) à la dose de 200mg/j. La propriétaire veille à une éviction solaire surtout lors du soleil estival de 10h à 18h, un application d’écran total est utilisée sur le chanfrein si nécessaire.
Après quinze jours, les lésions ont bien diminué et la dose de prednisolone est passée à 1mg/Kg/j. Quinze jours plus tard, les corticoïdes ne sont plus donnés qu’un jour sur deux.
Après un mois en thérapie à jours alternés, il ne persiste que trois points dépigmentés sur la truffe et un sevrage progressif de la prednisolone est décidé.
Au sevrage de la cortisone, la guérison apparente est totale et tous les soins sont interrompus. Seul persiste la consigne d’éviter le soleil.
Aucune rechute n’est à signaler pendant les onze mois suivants dont un été complet.
Seize mois après l’arrêt du traitement, une zone érythémateuse est notée par la propriétaire à la jonction entre le chanfrein et la truffe et sur la paupière. Des biopsies confirment une récidive avec les mêmes caractères histologiques que précédemment. Les lésions de faible importance sont traitées avec des topiques corticoïdes dont un de classe I sur le chanfrein (Dermoval ND).
Après la deuxième récidive, les poils du cantus des yeux et du chanfrein ont repoussé et sont restés blancs.
Discussion
Le pemphigus érythémateux (P.E.) est une variante bénigne et localisée à la face du pemphigus foliacé (P.F.). Il ne semble pas avoir de prédisposition de sexe ni d’âge mais les Bergers Allemands et les Colleys semblent prédisposés. Cliniquement, il se limite à des lésions pustuleuses du chanfrein, des pavillons auriculaires et du tour des yeux. Ces pustules, superficielles comme dans le P.F., sont très transitoires et on observe plutôt une dermatose squamo-croûteuse, voire des collerettes épidermiques. Une dépigmentation notamment de la truffe est souvent notée et le P.E. doit être inscrit dans le diagnostic différentiel des dépigmentations de la truffe. Comme pour le lupus discoïde, les lésions sont photoaggravées.
Comme pour le lupus, l’histopathologie décrit une dermatite d’interface avec sa double base: dégénérescence hydropique des cellules de la basale et infiltrat lichénoïde avec incontinence pigmentaire. On trouve, en parallèle, les caractéristiques du pemphigus foliacé avec des pustules superficielles acantholytiques. Sur des pustules intactes ou sur le plancher de croûtes, on peut avoir un cytodiagnostic de Tzanck positif si l’on retrouve des polynucléaires non dégénérés et de nombreux acanthocytes avec parfois des images en ‘rosette’ ou en ‘roue crantée’. Le diagnostic est anatomo-pathologique, l’immunofluorescence offre trop de faux positifs et de faux négatifs pour être intéressante. Chez l’homme, il existe un test ELISA utilisant des desmogléines 1 (cible du P.F.) et 3 (cible du pemphigus vulgaire) qui donne une très bonne fiabilité dans le diagnostic des pemphigus.
Le traitement utilise les corticoïdes à courte durée de vie (prednisone, prednisolone, méthylprednisolone) à raison de 2mg/Kg/j puis, après induction la plus courte possible, passage à une dose inférieure et à une thérapie à jours alternés pour limiter les effets secondaires néfastes, jusqu’à trouver la plus petite dose efficace, le sevrage n’étant pas toujours possible. Si la cortisone est mal supportée ou inefficace on peut ajouter ou substituer l’aziathroprine, le chlorambucil voire le cyclophosphamide ou des sels d’or (aurothiglucose) comme dans le P.F. mais il faut toujours évaluer les retentissements pathologiques de la maladie versus ceux de la thérapie. La ciclosporine et la dapsone ne semble pas donner de bons résultats. Le caractère limitée de la dermatose fait préférer, sauf lésions ulcéreuses et/ou trop conséquentes, un traitement topique faisant appel au départ à un dermocorticoïde de classe I ou II puis passage à un dermocorticoïde de classe supérieure après amélioration. L’utilisation de l’association nicotinamide-tétracyclines (500mg de chaque, 3 fois par jour, pour un chien de plus de 20kg, ½ dose pour un chien de moins de 20kg) ou de doxycycline est proposée. La vitamine E et les acides gras ont été préconisés pour leur effet antioxydant. Il ne faut pas oublier la photoaggravation et l’éviction solaire est un facteur important de la réussite.
Références
- Bensignor E., Carlotti D.N.: Diagnostic des dermatoses pustuleuses du chien, Prat. Med. Chir. Anim. Comp., 1998, 33 (6), p. 455-468
- De Geyer G.: Dermatologie des paupières du chien et du chat 2eme partie, Prat. Med. Chir. Anim. Comp., 1993, 28 (6), p. 613-625.
- Scott D.W., Miller W.H. and Grifin C.E.: Small animal dermatology, 5 th Ed., WB Saunders, Philadelphia , 1995.
- Calotti D.N, Von Tscharner C.: Pemphigus foliacé: Polémique, et Bensignor E., Degorce F.: le lupus discoïde canin existe-t-il? In Proceedings ‘Controverses de fin de siècle’, 15èmes Journées du GEDAC, Marseille 3-4 juin 2000
Pour en savoir plus
- Tous les articles disponibles sur le moteur de recherche de Dermavet.